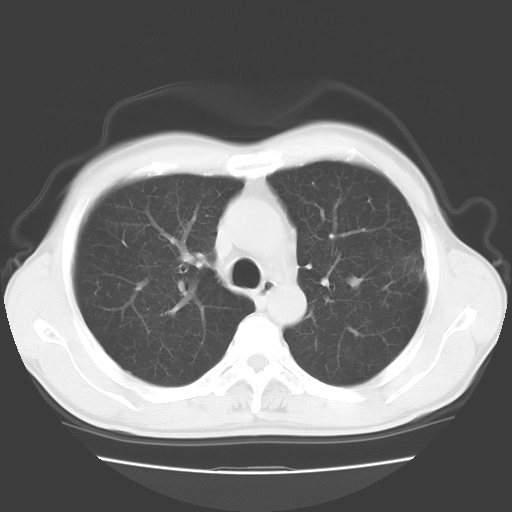

以下是引用随光逐影在2008-11-20 23:02:00的发言:[br]1)考虑左肺上叶周围型肺癌可能性大。2)两肺散在性肺泡积血。[br][br][本贴已被 随光逐影 于 2008-11-20 23:09:31 修改过]
以下是引用drzhang8888在2008-11-20 22:20:00的发言:[br]密集的短毛刺,血管集束,胸膜凹陷,周边型肺癌可能性大,另双肺多发磨玻璃影,考虑感染
以下是引用流浪星在2008-11-20 22:28:00的发言:[br]左肺上叶近外围区见一类圆形结节影,毛刺征、胸膜尾征阳性,临近肺组织见多发渗出灶。考虑1,炎症性病变。 2.周围性肺癌。建议抗炎治疗后复查。
以下是引用drzhang8888在2008-11-20 22:20:00的发言:[br]密集的短毛刺,血管集束,胸膜凹陷,周边型肺癌可能性大,另双肺多发磨玻璃影,考虑感染
以下是引用qc80012345在2008-11-21 5:53:00的发言:[br]支持;周围型肺癌诊断。增强扫描。
| 欢迎光临 医影在线 (http://bbs.radida.com/bbs/) | Powered by Discuz! X3.2 |